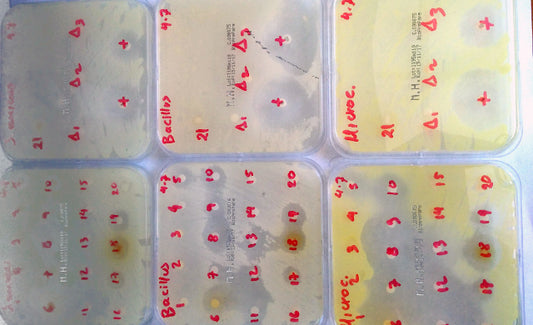

Εργαστήρι της Φύσης

Περίληψη ανακοίνωσης στο 7ο Συνέδριο Μυκητολογίας
Συμμετέχουμε με ανακοίνωση των ερευνητικών μας αποτελεσμάτων στο 7ο Πανελλήνιο Συνέδριο Ελληνικής Εταιρείας Ιατρικής Μυκητολογίας, 3-5 Νοεμβρίου 2017. Το θέμα του συνεδρίου είναι: "Μυκητιακές λοιμώξεις: μια συνεχής πρόκληση" Περίληψη: ΑΝΤΙΜΥΚΗΤΙΑΚΗ...
Περίληψη ανακοίνωσης στο 7ο Συνέδριο Μυκητολογίας
Συμμετέχουμε με ανακοίνωση των ερευνητικών μας αποτελεσμάτων στο 7ο Πανελλήνιο Συνέδριο Ελληνικής Εταιρείας Ιατρικής Μυκητολογίας, 3-5 Νοεμβρίου 2017. Το θέμα του συνεδρίου είναι: "Μυκητιακές λοιμώξεις: μια συνεχής πρόκληση" Περίληψη: ΑΝΤΙΜΥΚΗΤΙΑΚΗ...

Πλήθος επιστημόνων στο 15ο Επιστημονικό Συνέδρι...
Στο Συνεδριακό Κέντρο του Μεσογειακού Αγρονομικού Ινστιτούτου Χανίων, από 14 έως 17 Σεπτεμβρίου, έλαβε χώρα το 15ο Πανελλήνιο Επιστημονικό Συνέδριο της Ελληνικής Βοτανικής Εταιρείας, όπου παρουσιάστηκε το πρώτο κομμάτι της επιστημονικής...
Πλήθος επιστημόνων στο 15ο Επιστημονικό Συνέδρι...
Στο Συνεδριακό Κέντρο του Μεσογειακού Αγρονομικού Ινστιτούτου Χανίων, από 14 έως 17 Σεπτεμβρίου, έλαβε χώρα το 15ο Πανελλήνιο Επιστημονικό Συνέδριο της Ελληνικής Βοτανικής Εταιρείας, όπου παρουσιάστηκε το πρώτο κομμάτι της επιστημονικής...
Περίληψη ανακοίνωσης στο Συνέδριο
Ελληνική φυτική βιοποικιλότητα: Αξιοποίηση αντιμικροβιακής δράσης αιθερίων ελαίων και εκχυλισμάτων αρωματικών και φαρμακευτικών φυτών. Plant biodiversity of Greece: Utilization of aromatic and medicinal plants’ essential oils and extracts for their...
Περίληψη ανακοίνωσης στο Συνέδριο
Ελληνική φυτική βιοποικιλότητα: Αξιοποίηση αντιμικροβιακής δράσης αιθερίων ελαίων και εκχυλισμάτων αρωματικών και φαρμακευτικών φυτών. Plant biodiversity of Greece: Utilization of aromatic and medicinal plants’ essential oils and extracts for their...

Η Mellifora στηρίζει την έρευνα σε συνεργασία μ...
Ξεκίνησε η ερευνητική εργασία με τίτλο "Αρωματικά & Φαρμακευτικά Φυτά προστατεύουν την υγεία μας και συντηρούν τα καλλυντικά μας". Στόχος της Mellifora είναι να καταφέρει να φτιάξει καλλυντικά χωρίς χημικά...
Η Mellifora στηρίζει την έρευνα σε συνεργασία μ...
Ξεκίνησε η ερευνητική εργασία με τίτλο "Αρωματικά & Φαρμακευτικά Φυτά προστατεύουν την υγεία μας και συντηρούν τα καλλυντικά μας". Στόχος της Mellifora είναι να καταφέρει να φτιάξει καλλυντικά χωρίς χημικά...

Αξιολόγηση προϊόντων
... Ο Ορός ημέρας είναι καλός και ελαφρύς στο πρόσωπο γιατί δεν χρειάζεται μεγάλη ποσότητα. To lip balm επίσης είναι καλό και έχει ωραία αίσθηση. Τέλος βρήκα πολύ ωραίο το...
Αξιολόγηση προϊόντων
... Ο Ορός ημέρας είναι καλός και ελαφρύς στο πρόσωπο γιατί δεν χρειάζεται μεγάλη ποσότητα. To lip balm επίσης είναι καλό και έχει ωραία αίσθηση. Τέλος βρήκα πολύ ωραίο το...

Λίγα λόγια τα προϊόντα σας. (αξιολόγηση)
...Σε γενικες γραμμές τα προιόντα μας έχουν καταπλήξει. Συγχαρητήρια. Οι μεγάλες βιομηχανίες που απευθυνονται στο ευρύ κοινό προσφέρουν πολύ λιγότερα όσον αφορα την αποτελεσματικότητα ή και τιποτα μερικές φορες, ...
Λίγα λόγια τα προϊόντα σας. (αξιολόγηση)
...Σε γενικες γραμμές τα προιόντα μας έχουν καταπλήξει. Συγχαρητήρια. Οι μεγάλες βιομηχανίες που απευθυνονται στο ευρύ κοινό προσφέρουν πολύ λιγότερα όσον αφορα την αποτελεσματικότητα ή και τιποτα μερικές φορες, ...